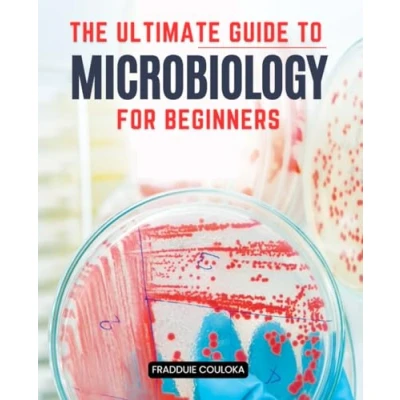

The Ultimate Guide to Microbiology for Beginners: Understanding Bacteria, Viruses, Fungi, and Parasites Tackle Human Health Issues
Pages: 140, Paperback, Independently published
 Price History
Price History
Prices were last updated on:

Product specifications
Product specifications Related
Related 



